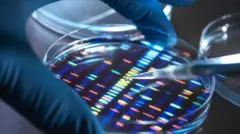
Cientista usando uma pipeta para pingar amostra em placa para teste de DNA em laboratório

Crédito, Getty Images
- Author, Adam Rutherford *
- Role, BBC Future
Quando os cientistas revelaram o primeiro rascunho do Projeto Genoma Humano, há 25 anos, ele parecia dar a palavra final em relação a alguns mitos ultrapassados sobre raça.
O projeto forneceu evidências definitivas de que os grupos raciais não têm base biológica. Na verdade, há mais variação genética dentro dos grupos raciais do que entre eles. A raça, como a iniciativa mostrou, é uma construção social.
Apesar desta descoberta fundamental, que só foi reforçada com o avanço da pesquisa sobre genomas humanos, a raça e a etnia ainda são usadas com frequência para categorizar as populações humanas como grupos biológicos distintos.
São visões que podem ser encontradas circulando na pseudociência das redes sociais, mas também ainda se infiltram na pesquisa científica e nos sistemas de saúde.
É ainda mais preocupante quando este pensamento chega aos corredores do poder.
O presidente dos Estados Unidos, Donald Trump, e seu governo não escondem sua rejeição a vários aspectos da visão científica do mundo.
Desde que retornou à Casa Branca, ele fez cortes drásticos no financiamento científico para pesquisas biomédicas e climáticas, mas em uma ordem executiva recente, Trump mirou no que a maioria dos cientistas agora considera como uma realidade biológica.
Intitulado “Restaurando a verdade e a sanidade na história americana”, o decreto presidencial, assinado por Trump, teve como alvo uma exposição chamada A forma do poder: histórias de raça e escultura americana no Museu de Arte Americana do Instituto Smithsonian.
A ordem executiva faz parte de uma tentativa mais ampla de moldar a cultura americana, eliminando “ideologias impróprias, divisivas ou antiamericanas” dos museus do instituto.
Ela afirma: “Os museus da capital da nossa nação devem ser lugares onde as pessoas vão para aprender — não para serem submetidas a doutrinação ideológica ou narrativas divisivas que distorcem nossa história compartilhada.”
A exposição em si é criticada no texto por promover a ideia de que “a raça não é uma realidade biológica, mas uma construção social, afirmando que ‘a raça é uma invenção humana'”.
A ordem executiva apresenta a exposição como um exemplo de uma mudança “prejudicial e opressiva” na narrativa que retrata os valores americanos.
Este é o ponto em que pessoas como eu, um geneticista especializado na história da ciência racial, ficam um pouco irritadas.

Crédito, Getty Images
A questão aqui é que a frase citada pelo Instituto Smithsonian está 100% correta.
Isso não é controverso nem na ciência nem na história.
A variação humana é, obviamente, bastante real. As pessoas são diferentes, e podemos ver essas diferenças na pigmentação da pele, na cor e na textura do cabelo e em outras características físicas.
Essas diferenças se agrupam em locais ao redor do mundo: pessoas da mesma região, em média, são mais parecidas entre si do que com pessoas de outras áreas — até aí, tudo óbvio.
No século 18, estas características foram os principais fatores determinantes de uma nova forma de categorizar os seres humanos em termos supostamente científicos.
O botânico sueco Karl Linnaeus é considerado legitimamente como o pai da biologia moderna, uma vez nos forneceu o sistema de classificação que usamos até hoje: gênero e espécie.
Todo ser vivo é nomeado de acordo com este sistema — por exemplo, a bactéria Escherichia coli, o leão, Panthera leo, ou o Gorilla gorilla, que provavelmente dispensa apresentações. Nós somos Homo sapiens — pessoas sábias.
Mas em sua obra fundamental, intitulada Systemae Naturae, Linnaeus introduziu outro nível de classificação para nós, designado principalmente pela mais visível das características humanas: a pigmentação.
Linnaeus estabeleceu quatro tipos de seres humanos, agrupados por massas terrestres continentais: Asiaticus — pessoas com “pele amarela” e cabelo liso preto; Americanus — indígenas americanos, com “pele vermelha”, e também cabelo liso preto; Africanus — pessoas de “pele preta” e cabelo crespo; e Europaeus — de “pele branca” com olhos azuis.
Estas designações são claramente absurdas — nenhuma das cores é precisa, mesmo se você adotasse a visão obviamente incorreta de que milhões de pessoas compartilham os mesmos tons de pele, inclusive dentro destas categorias.
Mas as raízes das designações raciais que usamos ainda hoje são visíveis nesses rótulos.
Alguns destes termos deixaram de ser aceitos socialmente, e são considerados racistas. Mas ainda usamos “negro” e “branco” para descrever milhões de pessoas, nenhuma das quais realmente tem pele negra ou branca.
Mesmo que esse esquema de cores fosse verdadeiro, as descrições originais de Linnaeus apenas começaram com características físicas.
O que ele incluiu em edições posteriores do Systemae Naturae, que se tornou a base do racismo científico, foram retratos de comportamentos.
Os Asiaticus foram descritos como “arrogantes, gananciosos e regidos por opiniões”, enquanto os Americanus foram rotulados como “teimosos, fervorosos e regidos pelos costumes”.
As mulheres Africanus foram descritas como “sem vergonha”, enquanto ambos os sexos foram considerados “astutos, preguiçosos e regidos pelo capricho”.
Ele descreveu os Europaeus como “gentis, perspicazes, inventivos e regidos por leis”.
Por qualquer definição e em qualquer época, estas afirmações são racistas e totalmente incorretas.
É claro que, ao examinar a história, devemos ter cuidado ao julgar as pessoas do passado com base em nossos próprios padrões.
Mas, como texto fundamental da biologia moderna, a introdução de um sistema de classificação para os seres humanos que é absurdo, racista e, acima de tudo, hierárquico, deixaria uma marca indelével nos séculos seguintes.

Crédito, Getty Images
Nos 200 anos seguintes, muitos homens buscaram refinar essas categorias com novas métricas, incluindo interpretações pseudocientíficas da craniometria, ou medidas do crânio.
Eles nunca chegaram a uma resposta definitiva sobre quantas raças existem — nenhuma das características que estavam sendo usadas é imutável nem exclusiva das pessoas para as quais elas eram supostamente essenciais.
Chamamos esta ideologia de “essencialismo racial”. Mas todos os vários esquemas colocavam os europeus brancos como superiores a todos os outros.
Foi o biólogo Charles Darwin quem primeiro começou a desconstruir essas ideias, reconhecendo em seu livro de 1871, A Origem do Homem, que havia muito mais continuidade nas características entre pessoas que haviam sido designadas como raças distintas.
No início do século 20, a biologia molecular entrou em cena, e a era da genética desmantelou o conceito biológico de raça.
Quando começamos a analisar como os genes são compartilhados em famílias e populações, vimos que as semelhanças de fato se aglomeram em grupos, mas esses agrupamentos não se alinham com as tentativas de longa data de classificar as raças. A verdadeira métrica da diferença humana é a nível genético.
No século 20, quando começamos a desvendar nossos genomas, e a observar como as pessoas são semelhantes e diferentes em relação ao DNA, vimos que os termos em uso há vários séculos tinham pouca relação significativa com a genética subjacente.
Embora apenas uma pequena porcentagem do nosso DNA seja diferente entre os indivíduos, o genoma é tão grande e complexo que há uma grande diversidade.
Os geneticistas ainda estão trabalhando para desvendar como isso altera a saúde das pessoas, por exemplo.
Mas essas diferenças genéticas não se definem de acordo com o que chamamos de raça. Elas seguem linhagens ancestrais, podem diferir de acordo com a localização geográfica e podem ser rastreadas por meio de padrões históricos de migração.
O que sabemos agora é que há mais diversidade genética em pessoas de ascendência africana recente do que no resto do mundo junto.
Pegue duas pessoas, por exemplo, da Etiópia e da Namíbia, e elas serão mais diferentes entre si a nível genético do que uma delas é em relação a um europeu branco, ou até mesmo um japonês, um inuíte ou um indiano.
Isso inclui os genes que estão envolvidos na pigmentação.
No entanto, por razões históricas, continuamos a nos referir tanto aos etíopes quanto aos namíbios sob a definição de raça “negra”.
Vejamos o exemplo dos afro-americanos, pessoas que descendem em grande parte de africanos escravizados levados para o Novo Mundo.
O sequenciamento dos genomas dos negros americanos revela ecos da história da escravidão transatlântica.
Eles não só misturaram a ascendência genética de alguns países da África Ocidental de onde seus ancestrais foram retirados, mas também quantidades significativas de DNA de europeus brancos.
Isso reflete o fato de que os proprietários de pessoas escravizadas mantinham relações sexuais — muitas das quais não eram consensuais — com escravizados.
Portanto, a simples categorização dos descendentes dos escravizados como “negros” também não faz sentido do ponto de vista biológico.
Eles são geneticamente diversos por si só, e diferentes dos ancestrais africanos dos quais descendem. Colocá-los juntos não faz sentido do ponto de vista científico.
Portanto, é por consenso, uso e história que continuamos a usar o termo “negro”. Isso é o que queremos dizer com uma construção social.
O conceito de raça tem pouca utilidade como taxonomia biológica. Mas é extremamente importante do ponto de vista social e cultural.
As construções sociais são a forma como o mundo funciona: dinheiro e tempo também são construídos socialmente.
O valor de uma libra ou dólar é aplicado em relação a bens e serviços. O tempo passa de forma infalível, mas horas e minutos são unidades totalmente arbitrárias.
Portanto, embora a raça não seja biologicamente significativa, ela tem consequências biologicamente significativas.
O impacto da maioria das doenças está relacionado à pobreza. Como as pessoas com ascendência de minorias étnicas tendem a apresentar níveis mais baixos de status socioeconômico, as doenças tendem a afetá-las de forma mais grave.
Isso é verdade em todas os aspectos, mas ficou evidente logo no início da pandemia de covid-19. Negros, sul-asiáticos e, nos Estados Unidos, hispânicos foram desproporcionalmente infectados e morreram em decorrência da doença.
A imprensa imediatamente começou a procurar um motivo que materializasse a versão biológica da raça, às vezes com foco no metabolismo da vitamina D, que está ligado à produção de melanina e tem efeitos sobre infecções virais.
Alguns estudos mostraram que níveis mais baixos de vitamina D estavam de fato associados à suscetibilidade à infecção por covid-19 entre os negros. Mas isso é uma correlação, não uma causa.
Crédito, Getty Images
Por trás de qualquer pequena diferença biológica, estão causas muito mais fortes: enquanto muitos de nós estávamos confinados em casa, os trabalhadores da linha de frente do NHS (sistema público de saúde britânico), as pessoas que limpam nosso lixo e dirigem nossos ônibus tinham maior probabilidade de pertencer a minorias étnicas.
Elas simplesmente tinham um risco maior de serem expostas e, portanto, infectadas pelo vírus. Combine isso com o fato de que os grupos minoritários têm maior probabilidade de viver em moradias urbanas densas e multigeracionais, e a suposta suscetibilidade biológica desaparece.
É por isso que a genética desempenha um papel tão importante no desmantelamento de uma justificativa científica da raça e na compreensão do próprio racismo.
E é por isso que a recente declaração da Casa Branca está preocupando muitos na comunidade científica.
Trump fala com frequência sobre aspectos da genética para defender argumentos políticos. Uma opinião que ele manifestou repetidamente é que algumas pessoas, e de forma previsível, ele próprio, são geneticamente superiores.
“Vocês têm bons genes, vocês sabem disso, certo?”, ele disse em setembro de 2020 durante um comício em Minnesota, estado americano com mais de 80% de população branca.
“Vocês têm bons genes. Muito disso tem a ver com os genes, não é, vocês não acreditam? Vocês têm bons genes em Minnesota.”
Da mesma forma, na bem-sucedida campanha de 2024, ele denunciou os imigrantes como tendo “genes ruins”.
É difícil para alguém que estuda genes — e a estranha e, às vezes, perturbadora história da genética — entender até mesmo o que pode constituir um gene “bom” ou “ruim”.
Nossa história pode ser perniciosa, mas a trajetória da genética tem sido uma que tende ao progresso e à equidade para todos, conforme consagrado na Declaração de Independência dos Estados Unidos.
* Adam Rutherford é um geneticista e divulgador científico britânico. Ele foi apresentador dos programas Inside Science e The Human Subject da BBC Radio 4.
Fonte.:BBC NEWS BRASIL












